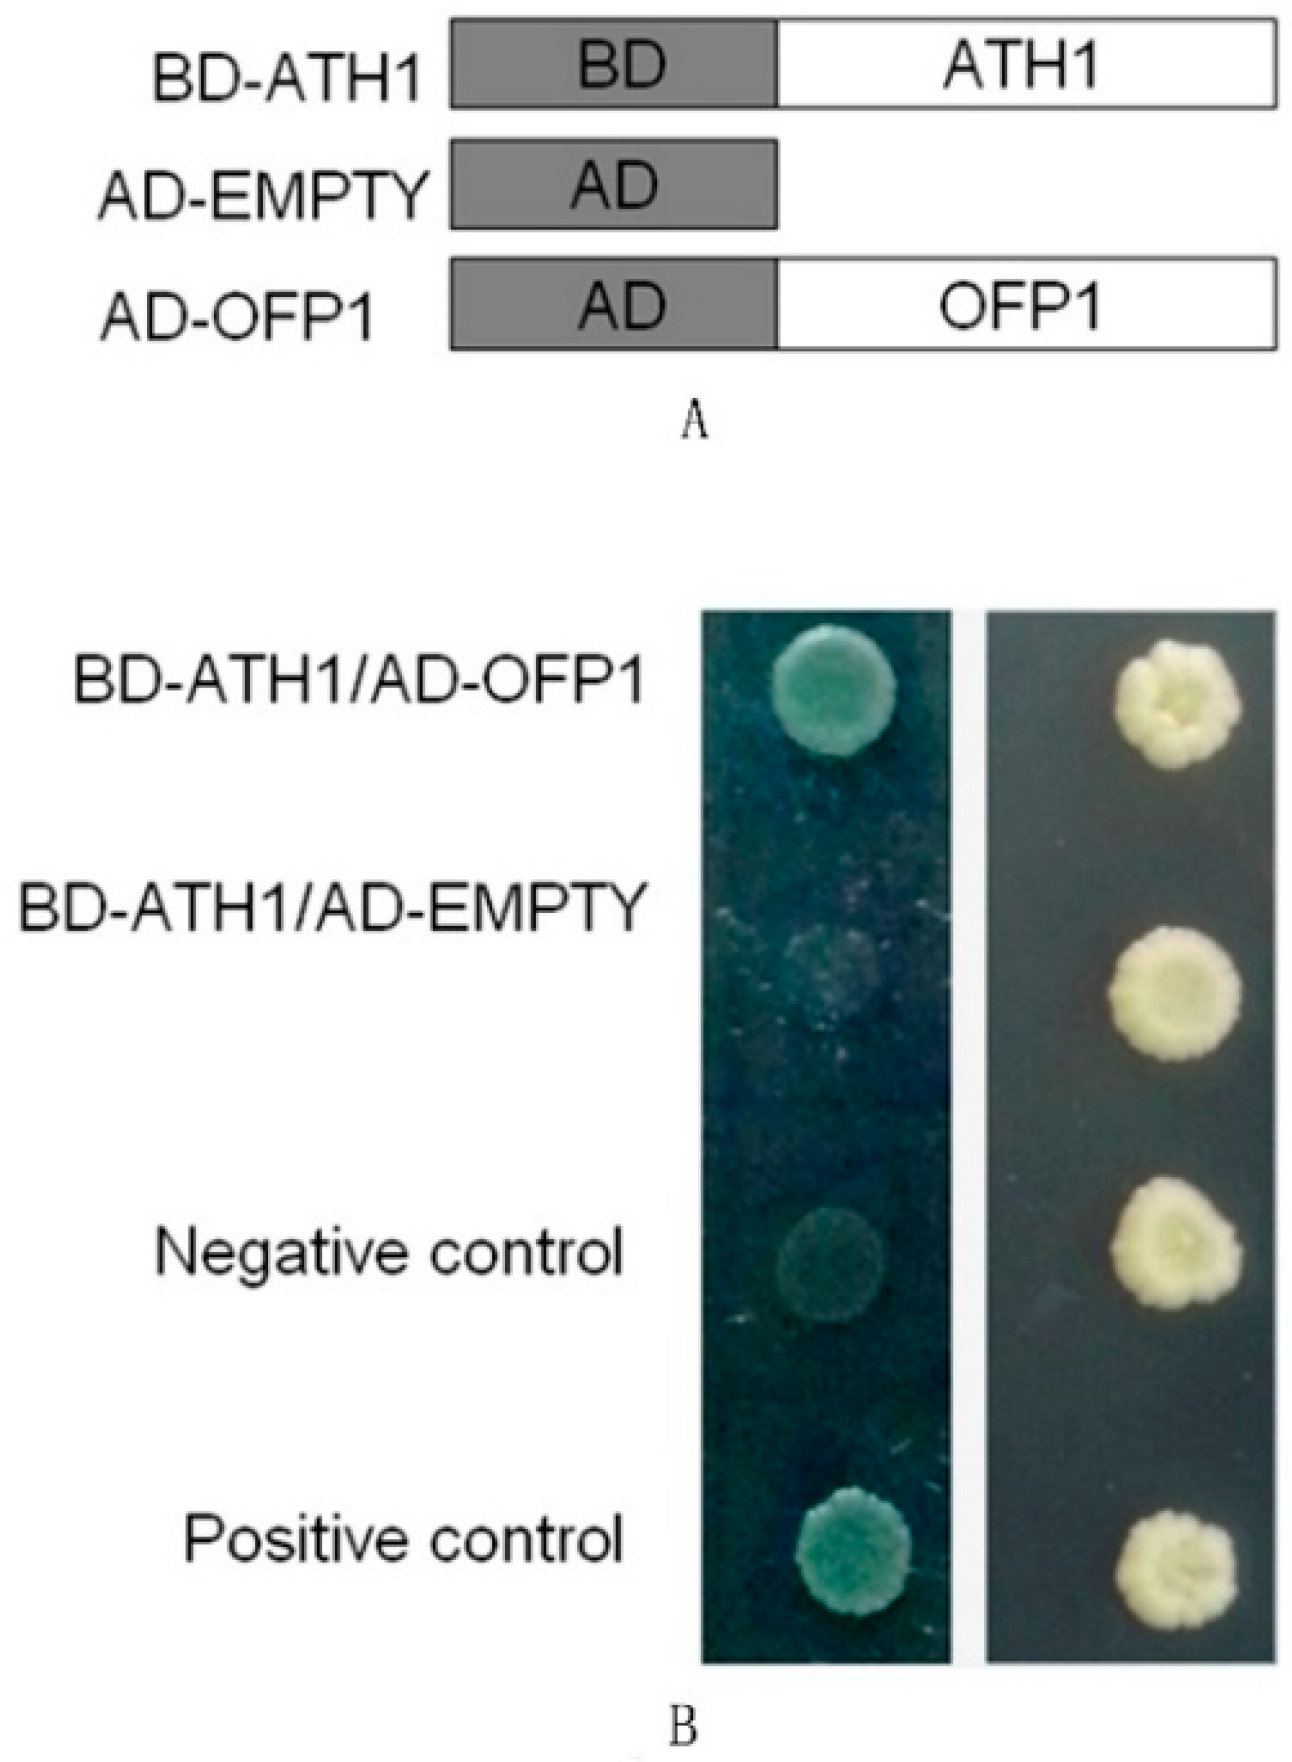
Genes 09 00399 g001 Genes 09 00399 g001

OFP1 Interaction with ATH1 Regulates Stem Growth, Flowering Time and Flower Basal Boundary Formation in Arabidopsis
Abstract
1. Introduction
2. Materials and Methods
2.1. Plant Materials
2.2. Plasmid Construction and Yeast Two-Hybrid System Testing
2.3. Bimolecular Fluorescence Complementation
2.4. Transient Transfection of Protoplasts and Plasmid Construction
2.5. Expression Assay of ATH1, Scanning Electron Microscopy and Cell Length
3. Results
3.1. Detection of Protein Interaction between ATH1 and OFP1
3.2. ATH1 Functions as a Transcriptional Repressor
3.3. Expression Pattern of ATH1 and OFP1
3.4. Role of OFP1 and ATH1 in Plant Development
4. Discussion
4.1. Interaction of OFP1 with ATH1 In Vivo for Repression of Transcription
4.2. The OFP1–ATH1 Protein Complex Is Involved in Regulating Flowering Time, Stem Growth, and Flower Basal Boundary Development
Supplementary Materials
Author Contributions
Funding
Acknowledgments
Conflicts of Interest
References
- Wang, S.; Chang, Y.; Guo, J.; Zeng, Q.; Ellis, B.E.; Chen, J.G. Arabidopsis ovate family proteins, a novel transcriptional repressor family, control multiple aspects of plant growth and development. PLoS ONE 2011, 6, 23896. [Google Scholar] [CrossRef] [PubMed]
- Gui, B.; Wang, Y. Cloning and sequence analysis of ovate orthologous gene in tobacco (Nicotiana tabacum L.). Plant Physiol. Commun. 2007, 43, 1050. [Google Scholar]
- Zhang, L.G.; Chang, Y.; Zhang, X.F.; Guan, F.Z.; Yuan, H.M.; Yu, Y.; Zhao, L.J. Analysis of the genetic diversity of Chinese native Cannabis sativacultivars by using ISSR and chromosome markers. Genet. Mol. Res. 2014, 13, 10490–10500. [Google Scholar] [CrossRef] [PubMed]
- Yu, H.; Jiang, W.; Liu, Q.; Zhang, H.; Piao, M.; Chen, Z.; Bian, M. Expression pattern and subcellular localization of the ovate protein family in rice. PLoS ONE 2015, 10, 0118966. [Google Scholar] [CrossRef] [PubMed]
- Wang, S.; Chang, Y.; Guo, J.; Chen, J.G. Arabidopsis Ovate Family Protein 1 is a transcriptional repressor that suppresses cell elongation. Plant J. 2007, 5, 858–872. [Google Scholar] [CrossRef] [PubMed]
- Hackbusch, J.; Richter, K.; Müller, J.; Salamini, F.; Uhrig, J.F. A central role of Arabidopsis thaliana ovate family proteins in networking and subcellular localization of 3-aa loop extension homeodomain proteins. Proc. Natl. Acad. Sci. USA 2005, 102, 4908–4912. [Google Scholar] [CrossRef] [PubMed]
- Hamant, O.; Pautot, V. Plant development: A TALE story. Comptes Rendus Biol. 2010, 333, 371–381. [Google Scholar] [CrossRef] [PubMed]
- Stammler, A.; Meyer, S.S.; Plant, A.R.; Townsley, B.T.; Becker, A.; Gleissberg, S. Duplicated STM-like KNOX I genes act in floral meristem activity in Eschscholzia californica (Papaveraceae). Dev. Ggenes Evol. 2013, 223, 289–301. [Google Scholar] [CrossRef] [PubMed]
- Ichihashi, Y.; Aguilar-Martínez, J.A.; Farhi, M.; Chitwood, D.H.; Kumar, R.; Millon, L.V.; Sinha, N.R. Evolutionary developmental transcriptomics reveals a gene network module regulating interspecific diversity in plant leaf shape. Proc. Natl. Acad. Sci. USA 2014, 111, 2616–2621. [Google Scholar] [CrossRef] [PubMed]
- Tsuda, K.; Hake, S. Diverse functions of KNOX transcription factors in the diploid body plan of plants. Curr. Opin. Plant Biol. 2015, 27, 91–96. [Google Scholar] [CrossRef] [PubMed]
- Liu, Y.; Douglas, C.J. A role for OVATE FAMILY PROTEIN1 (OFP1) and OFP4 in a BLH6-KNAT7 multi-protein complex regulating secondary cell wall formation in Arabidopsis thaliana. Plant Signal. Behav. 2015, 10, 7. [Google Scholar] [CrossRef] [PubMed]
- Zhang, L.; Zhang, X.; Ju, H.; Chen, J.; Wang, S.; Wang, H.; Chang, Y. Ovate family protein1 interaction with BLH3 regulates transition timing from vegetative to reproductive phase in Arabidopsis. Biochem. Biophys. Res. Commun. 2016, 470, 492–497. [Google Scholar] [CrossRef] [PubMed]
- Wang, S.; Chang, Y.; Ellis, B. Overview of OVATE FAMILY PROTEINS, a novel class of plant-specific growth regulators. Front. Plant Sci. 2016, 7, 1–9. [Google Scholar] [CrossRef] [PubMed]
- Pagnussat, G.C.; Yu, H.J.; Sundaresan, V. Cell-fate switch of synergid to egg cell in Arabidopsis eostre mutant embryo sacs arises from misexpression of the BEL1-like homeodomain gene BLH1. Plant Cell 2007, 19, 3578–3592. [Google Scholar] [CrossRef] [PubMed]
- Rutjens, B.; Bao, D.; Van Eck-Stouten, E.; Brand, M.; Smeekens, S.; Proveniers, M. Shoot apical meristem function in Arabidopsis requires the combined activities of three BEL1-like homeodomain proteins. Plant J. 2009, 58, 641–654. [Google Scholar] [CrossRef] [PubMed]
- Khan, M.; Tabb, P.; Hepworth, S.R. BLADE-ON-PETIOLE1 and 2 regulate Arabidopsis inflorescence architecture in conjunction with homeobox genes KNAT6 and ATH1. Plant Signal. Behav. 2012, 7, 788–792. [Google Scholar] [CrossRef] [PubMed]
- Khan, M.; Ragni, L.; Tabb, P.; Salasini, B.C.; Chatfield, S.; Datla, R.; Lock, J.; Kuai, X.; Despres, C.; Proveniers, M. Repression of lateral organ boundary genes by PENNYWISE and POUND-FOOLISH is essential for meristem maintenance and flowering in Arabidopsis thaliana. Plant Physiol. 2015. [Google Scholar] [CrossRef] [PubMed]
- Li, H.; Ma, M.L.; Luo, S.; Zhang, R.M.; Han, P.; Hu, W. Metabolic responses to ethanol in Saccharomyces cerevisiae using a gas chromatography tandem mass spectrometry-based metabolomics approach. Int. J. Biochem. Cell Biol. 2012, 44, 1087–1096. [Google Scholar] [CrossRef] [PubMed]
- Cole, M.; Nolte, C.; Werr, W. Nuclear import of the transcription factor SHOOT MERISTEMLESS depends on heterodimerization with BLH proteins expressed in discrete sub-domains of the shoot apical meristem of Arabidopsis thaliana. Nucleic Acids Res. 2006, 34, 1281–1292. [Google Scholar] [CrossRef] [PubMed]
- Gómez-Mena, C.; Sablowski, R. ARABIDOPSIS THALIANA HOMEOBOX GENE1 establishes the basal boundaries of shoot organs and controls stem growth. Plant Cell 2008, 20, 2059–2072. [Google Scholar] [CrossRef] [PubMed]
- Clough, S.J.; Bent, A.F. Floral dip: A simplified method for Agrobacterium-mediated trans- formation of Arabidopsis thaliana. Plant J. 1998, 16, 735–743. [Google Scholar] [CrossRef] [PubMed]
- Zhang, X.; Henriques, R.; Lin, S.S.; Niu, Q.W.; Chua, N.H. Agrobacterium-mediated transformation of Arabidopsis thaliana using the floral dip method. Nat. Protoc. 2006, 1, 641. [Google Scholar] [CrossRef] [PubMed]
- Tzfira, T.; Tian, G.W.; Vyas, S.; Li, J.; Leitner-Dagan, Y.; Krichevsky, A.; Citovsky, V. pSAT vectors: A modular series of plasmids for autofluorescent protein tagging and expression of multiple genes in plants. Plant Mol. Biol. 2005, 57, 503. [Google Scholar] [CrossRef] [PubMed]
- Yoo, S.D.; Cho, Y.H.; Sheen, J. Arabidopsis mesophyll protoplasts: A versatile cell system for transient gene expression analysis. Nat. Protoc. 2007, 7, 1565–1572. [Google Scholar] [CrossRef] [PubMed]
- Tiwari, S.B.; Hagen, G.; Guilfoyle, T. The roles of auxin response factor domains in auxin-responsive transcription. Plant Cell 2003, 15, 533–543. [Google Scholar] [CrossRef] [PubMed]
- Wang, S.; Tiwari, S.B.; Hagen, G.; Guilfoyle, T.J. AUXIN RESPONSE FACTOR7 restores the expression of auxin-responsive genes in mutant Arabidopsis leaf mesophyll protoplasts. Plant Cell 2005, 17, 1979–1993. [Google Scholar] [CrossRef] [PubMed]
- Hajdukiewicz, P.; Svab, Z.; Maliga, P. The small, versatile pPZP family of Agrobacterium binary vectors for plant transformation. Plant Mol. Biol. 1994, 25, 989–994. [Google Scholar] [CrossRef] [PubMed]
- Tiwari, S.; Wang, S.; Hagen, G.; Guilfoyle, T.J. Transfection Assays with Protoplasts Containing Integrated Reporter Genes. In Arabidopsis Protocols; Humana Press: New York, NY, USA, 2006; pp. 237–244. [Google Scholar]
- Guo, J.; Chen, J.G. RACK1 genes regulate plant development with unequal genetic redundancy in Arabidopsis. BMC Plant Biol. 2008, 8, 108. [Google Scholar] [CrossRef] [PubMed]
- Li, E.; Wang, S.; Liu, Y.; Chen, J.G.; Douglas, C.J. OVATE FAMILY PROTEIN4 (OFP4) interaction with KNAT7 regulates secondary cell wall formation in Arabidopsis thaliana. Plant J. 2011, 67, 328–341. [Google Scholar] [CrossRef] [PubMed]
- Tiwari, S.B.; Hagen, G.; Guilfoyle, T.J. Aux/IAA proteins contain a potent transcriptional repression domain. Plant Cell 2004, 16, 533–543. [Google Scholar] [CrossRef] [PubMed]
- Wang, Z.W.; Wu, Z.; Raitskin, O.; Sun, Q.; Dean, C. Antisense-mediated FLC transcriptional repression requires the P-TEFb transcription elongation factor. Proc. Natl. Acad. Sci. USA 2014, 111, 7468–7473. [Google Scholar] [CrossRef] [PubMed]
- Putterill, J.; Laurie, R.; Macknight, R. It’s time to flower: The genetic control of flowering time. Bioessays 2004, 26, 363–373. [Google Scholar] [CrossRef] [PubMed]
- Sheldon, C.C.; Rouse, D.T.; Finnegan, E.J.; Peacock, W.J.; Dennis, E.S. The molecular basis of vernalization: The central role of FLOWERING LOCUS C (FLC). Proc. Natl. Acad. Sci. USA 2000, 97, 3753–3758. [Google Scholar] [CrossRef] [PubMed]
- Susila, H.; Jin, S.; Ahn, J.H. Light intensity and floral transition: Chloroplast Says “Time to Flower!”. Mol. Plant 2016, 9, 1551–1553. [Google Scholar] [CrossRef] [PubMed]
- Bellaoui, M.; Pidkowich, M.S.; Samach, A.; Kushalappa, K.; Kohalmi, S.E.; Modrusan, Z.; Haughn, G.W. The Arabidopsis BELL1 and KNOX TALE homeodomain proteins interact through a domain conserved between plants and animals. Plant Cell 2001, 13, 2455–2470. [Google Scholar] [CrossRef] [PubMed]
- Müller, J.; Wang, Y.; Franzen, R.; Santi, L.; Salamini, F.; Rohde, W. In vitro interactions between barley TALE homeodomain proteins suggest a role for protein–protein associations in the regulation of Knox gene function. Plant J. 2001, 27, 13–23. [Google Scholar] [CrossRef] [PubMed]
- Proveniers, M.; Rutjens, B.; Brand, M. The Arabidopsis TALE homeobox gene ATH1 controls floral competency through positive regulation of FLC. Plant J. 2007, 52, 899–913. [Google Scholar] [CrossRef] [PubMed]
- Jacobs, T. Why do plant cells divide. Plant Cell 1997, 9, 1021. [Google Scholar] [CrossRef] [PubMed]
- Zhang, D.; Ren, L.; Yue, J.H.; Shi, Y.B.; Zhuo, L.H.; Wang, L.; Shen, X.H. RNA-seq-based transcriptome analysis of stem development and dwarfing regulation in Agapanthus praecox ssp. orientalis (Leighton) Leighton. Gene 2015, 565, 252–267. [Google Scholar] [CrossRef] [PubMed]

| Leaf Number at Flowering | Plastochron Day/Leaf | Inflorescence Height (cm) | |
|---|---|---|---|
| Col | 13.7 (±0.73) e | 1.45 (±0.14) bc | 8.7 (±0.62) d |
| ofp1 | 11.8 (±0.62) f | 1.49 (±0.10) ab | 9.6 (±0.83) c |
| ath1 | 10.1 (±0.81) g | 1.42 (±0.21) c | 10.3 (±0.63) b |
| 35S:OFP1 | 15.5 (±0.72) c | 1.43 (±0.09) c | 7.1 (±0.62) f |
| 35S:ATH1 | 17.1 (±0.80) a | 1.52 (±0.11) a | 1.4 (±0.62) h |
| 35S:OFP1/ath1 | 15.1 (±0.67) d | 1.45 (±0.15) bc | 8.1 (±0.81) e |
| 35S:ATH1/ofp1 ath1 ofp1 | 16.3 (±0.79) b 9.9 (±0.87) g | 1.49 (±0.14) ab 1.41 (±0.20) c | 2.9 (±0.86) g 10.7 (±0.91) a |
© 2018 by the authors. Licensee MDPI, Basel, Switzerland. This article is an open access article distributed under the terms and conditions of the Creative Commons Attribution (CC BY) license (http://creativecommons.org/licenses/by/4.0/).
Share and Cite
Zhang, L.; Sun, L.; Zhang, X.; Zhang, S.; Xie, D.; Liang, C.; Huang, W.; Fan, L.; Fang, Y.; Chang, Y. OFP1 Interaction with ATH1 Regulates Stem Growth, Flowering Time and Flower Basal Boundary Formation in Arabidopsis. Genes 2018, 9, 399. https://doi.org/10.3390/genes9080399
Zhang L, Sun L, Zhang X, Zhang S, Xie D, Liang C, Huang W, Fan L, Fang Y, Chang Y. OFP1 Interaction with ATH1 Regulates Stem Growth, Flowering Time and Flower Basal Boundary Formation in Arabidopsis. Genes. 2018; 9(8):399. https://doi.org/10.3390/genes9080399
Chicago/Turabian StyleZhang, Liguo, Lili Sun, Xiaofei Zhang, Shuquan Zhang, Dongwei Xie, Chunbo Liang, Wengong Huang, Lijuan Fan, Yuyan Fang, and Ying Chang. 2018. "OFP1 Interaction with ATH1 Regulates Stem Growth, Flowering Time and Flower Basal Boundary Formation in Arabidopsis" Genes 9, no. 8: 399. https://doi.org/10.3390/genes9080399
APA StyleZhang, L., Sun, L., Zhang, X., Zhang, S., Xie, D., Liang, C., Huang, W., Fan, L., Fang, Y., & Chang, Y. (2018). OFP1 Interaction with ATH1 Regulates Stem Growth, Flowering Time and Flower Basal Boundary Formation in Arabidopsis. Genes, 9(8), 399. https://doi.org/10.3390/genes9080399

